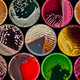
Barker culture plate1200x758

-
 Еще в 6 веке до н. э. Гипократ высказывал, что причиной заразных болезней являются невидимые живые существа. Первый микроскоп сконструировал в 1590г. В Голландии братья Янсены, он давал увеличение в 32 раза. Однако попытки использовать линзы, дающие большее увеличение, оказались неудачными, т.к. изображение становилось нерезким.
Еще в 6 веке до н. э. Гипократ высказывал, что причиной заразных болезней являются невидимые живые существа. Первый микроскоп сконструировал в 1590г. В Голландии братья Янсены, он давал увеличение в 32 раза. Однако попытки использовать линзы, дающие большее увеличение, оказались неудачными, т.к. изображение становилось нерезким. -
 В 1673 голландский натуралист Антинио Левунгук (1632—1723), который в свободное время шлифовал увеличительные стекла и рассматривал с их помощью мелкие предметы, изобрел микроскоп, который представлял собой двояковыпуклую линзу с очень коротким фокусным расстоянием. Он стал первым человеком, который увидел микробов с помощью изобретенного им микроскопа он описал их как «живых зверьков».
В 1673 голландский натуралист Антинио Левунгук (1632—1723), который в свободное время шлифовал увеличительные стекла и рассматривал с их помощью мелкие предметы, изобрел микроскоп, который представлял собой двояковыпуклую линзу с очень коротким фокусным расстоянием. Он стал первым человеком, который увидел микробов с помощью изобретенного им микроскопа он описал их как «живых зверьков».
В сентябре 1683г. Левенгук впервые приводит изображение бактерий шарообразной, палочковидной и извитой формы. -
 Между 1875 и 1878 г. Пастер формулирует «Теорию зародышей и ее применение в медицине и хирургии», которая явилась научной основой для изучения инфекционных заболеваний. В 1874 г. Джозеф Листер первый применил пастеровские принципы в хирургии, которые в связи с достижениями в области асептики получили самое широкое распространение. С 1884 г. стали применять вакцины с целью профилактики бешенства и заразных заболеваний; 1894 г. — год открытия серотерапии.
Между 1875 и 1878 г. Пастер формулирует «Теорию зародышей и ее применение в медицине и хирургии», которая явилась научной основой для изучения инфекционных заболеваний. В 1874 г. Джозеф Листер первый применил пастеровские принципы в хирургии, которые в связи с достижениями в области асептики получили самое широкое распространение. С 1884 г. стали применять вакцины с целью профилактики бешенства и заразных заболеваний; 1894 г. — год открытия серотерапии. -
 Микробиология начала развитие с изучения биохимической деятельности микроорганизмов и дала толчек бурному развитию общей, а затем и медицинской микробиологии, что неразрывно связанно с работами выдающегося ученого Луи Пастера (1822 -1895), который был по образованию химиком и его считают основателем микробиологии. Каждый из этапов своего творчества Пастер проводил как следственное дело: определял симптомы — улики, шаг за шагом реконструировал историю болезни.
Микробиология начала развитие с изучения биохимической деятельности микроорганизмов и дала толчек бурному развитию общей, а затем и медицинской микробиологии, что неразрывно связанно с работами выдающегося ученого Луи Пастера (1822 -1895), который был по образованию химиком и его считают основателем микробиологии. Каждый из этапов своего творчества Пастер проводил как следственное дело: определял симптомы — улики, шаг за шагом реконструировал историю болезни. -
 Развивался во второй половине 20 веке, в генетике, биотехнологии, генной инженерии, цитологии дало толчок к развитии микробиологии и иммунологии (молекул и генетических аспектов). Была расшифрована молекулярная структура бактерий и вирусов, строение и состав генома, структура факторов иммунной защиты. В результате достижения в микробиологии и иммунологии 20 века в обеспечили успехи в борьбе с инфекционными болезнями, открыли новые пути и методы диагностики.
Развивался во второй половине 20 веке, в генетике, биотехнологии, генной инженерии, цитологии дало толчок к развитии микробиологии и иммунологии (молекул и генетических аспектов). Была расшифрована молекулярная структура бактерий и вирусов, строение и состав генома, структура факторов иммунной защиты. В результате достижения в микробиологии и иммунологии 20 века в обеспечили успехи в борьбе с инфекционными болезнями, открыли новые пути и методы диагностики.
Want to make a timeline like this?
Use Timetoast to turn dates, events, milestones, and phases into a clear visual timeline you can build and share. Timetoast is a timeline maker for work, school, research, and stories.